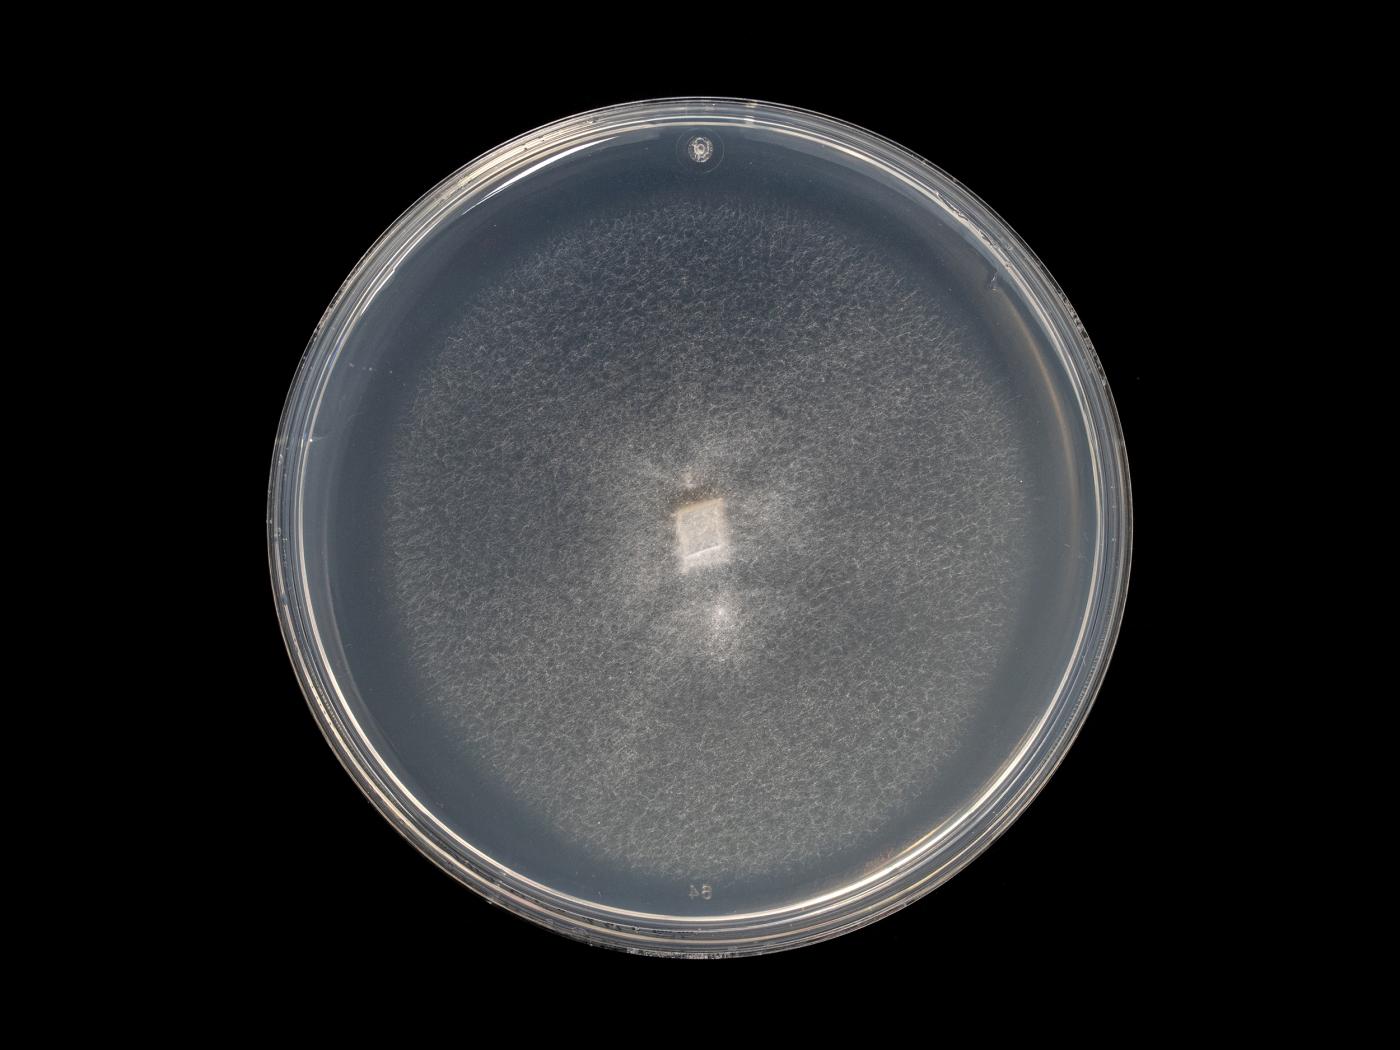

Conidies : Proviennent des apex des phialides, de forme ellipsoïdale ou irrégulièrement cylindrique, hyalines, en majorité simple et peuvent être occasionnellement avoir une septation. Dimension : 2,5-8 x 1,4-3,2 μm.
Conidiophores : Abondants, hyalins, portant de 3 à 4 phialides qui surgissent à chaque noeud. Les phialides varient en leur grosseur (dimension généralement de 16-35 x 1-2,5 μm).
Microsclérotes : Surgissent de façon centrale aux cultures. De teinte brune foncée à noire, formées en botryose ou cylindrique (formé de cellules globulaires). Chaque microsclérote émerge d'un hyphe simple par bourgeonnement. De forme variable (élongé à une sphère imparfaite). Très variable en grosseur. Diamètre: 15-100 μm.
Chlamydospores : Absentes.
Le champignon Verticillium dahliae peut affecter les cultures suivantes : abricotier, amaryllis, argousier, aubergine, bleuet nain, bleuet en corymbe, cerisier, chèvrefeuilles, chrysanthèmes, citrouille, concombre, épinard, épine-vinette du japon, érables, fraise, framboise rouge, framboise noire, géraniums (pélargoniums), ginseng d’amérique, houblon, ketmie, marguerites, melons (cantaloup, melon miel, etc.), menthe, muflier, ormes, pêcher, pétunias, piment, poivron, pomme de terre, potiron, reine-marguerite, rosiers, sarriette, tabac, tomate, tournesols et trèfle.
Noms des maladies des plantes au Canada. 4e éd. (2003). Société de protection des plantes du Québec (SPPQ), Sainte-Foy (Québec). 340 p.
International Mycological Institute (IMI). Descriptions of Fungi and Bacteria. CAB International (CABI), Kew, Surrey, United Kingdom.
Cultures ou autres organismes affectés
Aubergine
Aubergine - Verticilliose (Verticillium dahliae)_2
Aubergine - Verticilliose (Verticillium dahliae)_3
Aubergine - Verticilliose (Verticillium dahliae)_4
Aubergine - Verticilliose (Verticillium dahliae)_5
Concombre
Concombre - Verticilliose (Verticillium dahliae)_2
Fraise
Fraise - Verticilliose (Verticillium dahliae)_2
Pétunias
Pétunias - Verticilliose (Verticillium dahliae)_2
Pétunias - Verticilliose (Verticillium dahliae)_3
Pomme de terre
Pomme de terre - Verticilliose (Verticillium dahliae)_2
Pomme de terre - Verticilliose (Verticillium dahliae)
Pomme de terre - Verticilliose (Verticillium dahliae)